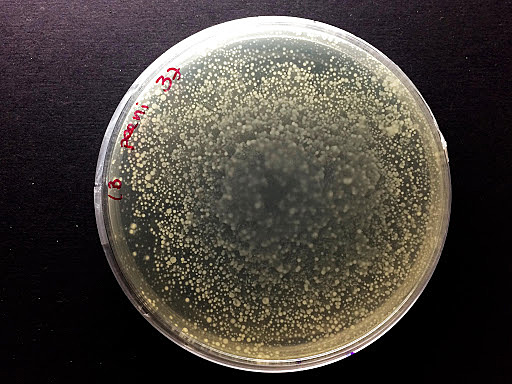
Cultivo selectivo de bacterias

-
Anteriormente los griegos y Romanos ya utilizaban las patas de palo pero las primeras prótesis similares a las actuales fueron desarrolladas por el médico francés Ambroise Paré.Fueron de gran ayuda para los soldados con algún miembro amputado(primer propósito) y hoy en día lo siguen siendo para cualquier dificultad de movilidad ausencia de alguna extremidad.Han ido evolucionando para ser cada vez más sofisticadas(antes eran de madera) y utilizadas
-
Edward Jenner utilizó la primera vacuna contra la viruela humana tras observar que las personas en contacto con vacas que sufrían la viruela bovina, presentaban inmunidad frente a la humana. Al inocular el virus vacuno, se consiguió que el humano no prosperase a través de la generación de ciertos anticuerpos.La esperanza de vida de las personas aumentó considerablemente al estar más protegidos ante enfermedades causadas por virus y bacterias que resultaban mortales para la población.
-
Anteriormente existía la creencia de que las enfermedades se producían por generación espontanea (establece que la vida surge a partir de objetos inanimados) pero Pasteur en el siglo XIX desmintió esta teoría mediante experimento de los caldos de carne esterilizados. Desde entonces se establecieron métodos de esterilización en los hospitales
-
Oliver Evnas diseñó la primera máquina de refrigeración. Hoy en día puede resultar muy obvio pero la aplicación de esta técnica,que permite garantizar la conservación correcta de algunos materiales como medicamentos, vacunas, suero, sangre, tejidos y órganos para trasplantes entre otros,ha sido una herramienta para grandes avances en medicina y su estudio.Además estos materiales podrán ser almacenados sin la necesidad de su aplicación inmediata y ser usados solo cuando sea requerido
-
A finales del siglo XIX, se utilizó por primera vez el eter etílico como sustancia anestésica, marcando así un antes y un después en el sufrimiento de los pacientes al realizarles operaciones quirúrgicas.Previamente en 1799, Humphry Davy asentó las bases para la anestesia con el el descubrimiento de la aplicación del óxido nitroso
-
La revolución ocurre en 1850 con la invención del oftalmoscopio por Helmholtz, que permite examinar el interior del ojo sin dañar al paciente. El desarrollo de esta ciencia ha ayudado a la mejora de calidad de vida de gran parte de la población con problemas de visión, ofreciéndonos desde cosas tan comunes para nosotros hoy en día como las gafas y lentillas, hasta procedimientos quirúrgicos de más calibre como las operaciones de cataratas o de lentes intraoculares.
-
Antes existía un alto porcentaje de muerte por infecciones postoperatorias. Joseph Lister introdujo la idea de la necesidad de desinfectar las heridas tras una operación (con ácido carbólico) y esto hizo evolucionar la cirugía de un alto riesgo de muerte hacia una práctica más segura y exitosa.
-
Esto ha contribuido notablemente en la prevención, diagnóstico, tratamiento y curación de enfermedades de origen genético, así como para el desarrollo de la terapia génica para enfermedades incurables. Además su estudio específico nos ofrece otras aplicaciones: obtención de hormonas y de vacunas recombinantes o transgénicas, abriendo así el camino al campo de la ingeniería genética, una disciplina relativamente nueva en pleno desarrollo, que supondrá el futuro de la medicina.
-
En 1881, Robert Koch diseñó un nuevo método para estudiar las bacterias, puesto que hasta entonces el estudio de estas se había realizado en medios líquidos (caldos) en los que no se podía aislarlas. Creó un cultivo de bacterias en un medio sólido que se encontraría dentro de la famosa cápsula de Petri.
A partir de ese momento se dio más importancia a la bacteriología, ya que esta ayudó a contrastar datos y establecer las causas de multitud de enfermedades bacterianas. -
Wilhelm Conrad Röntge descubrió el uso de los rayos X, ondas electromagnéticas que resultaban en una imagen del cuerpo en blanco y negro debido a la diferente capacidad de absorción de radiación de los diferentes tejidos. Esta nueva técnica permitió descubrir el interior del cuerpo humano sin necesidad de abrirlo
-
La primera transfusión exitosa fue en 1665 ,entre dos perros, pero no fue hasta 1901 que Karl Landsteiner descubrió los diferentes tipos de sangre existentes y así dar paso al uso de esta técnica de forma segura y exitosa ante rechazos.
-
En 1906, Mathieu Jaboulay publica el primer trasplante realizado en un ser humano, al que se le injertó un riñón procedente de un cerdo en el brazo. Sin embargo el riñón solo fue operativo durante una hora. Si bien es cierto que primero se realizaban en animales como perros y con órganos como riñones, la medicina ha avanzado mucho y hoy en día la tasa de éxito de los transplantes es bastante alta (llegando al 90% los renales) y se pueden transplantar muchos organos gracias a donantes.
-
Científicos de la Universidad de Toronto a la par que Nicolae Paulescu descubrieron cómo aislar la insulina,hormona antidiabética liberada del páncreas.Previamente, Oskar Minkowski y Joseph von Mering establecieron en 1889 la relación entre el páncreas y la patología de la diabetes que fueron los pasos previos al camino del descubrimiento de la insulina
Finalmente tras experimentos en perros y un niño de 14 años se determinó como remedio ante la enfermedad de la diabetes. -
Alexander Fleming descubre una sustancia de crecimiento natural que puede atacar a ciertas bacterias tras por accidente observar como un moho o hongo creció en una placa de bacterias en la que estaba estudiando y eliminó aquellas a su alrededor.Este moho fue a lo que él denominó penicillium. A partir de este descubrimiento ,investigadores y farmacéuticas se dieron cuenta de que servía para curar infecciones y salvar vidas
-
La warfarina se registró por primera vez para su uso como raticida en 1948. Sin embargo,tras el fallido intento de suicidio de un soldado mediante la ingesta de esta y su completa recuperación comenzaron los estudios en el uso de la warfarina como anticoagulante terapéutico. Su descubrimiento asentó las bases para el uso generalizado de anticoagulantes, sobretodo en operaciones quirúrgicas, evitando así un problema común y de alto riesgo:la coagulación sanginea en la trombosis
-
El primer fármaco para el VIH fue el AZT, que permitió frenar la replicación del virus y se convirtió en la primera terapia antirretroviral. Más tarde se lanzaron otros fármacos que mejoraron considerablemente la calidad de vida de los pacientes, haciendo su carga viral casi indetectable y permitiendo llevar una vida normal sin presentar síntomas y sin posibilidad de contagio a otras personas. Gracias al TAR se ha reducido la mortalidad por el VIH.
-
Fue a partir de la clonación de la oveja Dolly en 1996 que se planteó utilizar la clonación con fines terapéuticos.La clonación de células madre es útil y clave para desarrollar cualquier otra célula con distintas funciones para tratar diferentes patologías. Es una técnica pionera que puede suponer un gran avance pero actualmente está en desarrollo y en un delicado límite entre su utilidad y los derivados problemas éticos
-
Hasta el momento se había conseguido crear un cultivo de células madre embrionarias de ratones. Pero en 1998 un grupo de investigadores de la universidad de Wisconsin consiguió obtener el primer cultivo de células madre humanas, a las que se les atribuye gran cantidad de usos para fines terapéuticos. Estos incluyen tratamientos para enfermedades neurodegenerativas tales como el Alzheimer o el Parkinson, e incluso para la fabricación de tejidos para órganos destinados a transplantes.
A list shows items. A timeline shows sequence.
Use Timetoast to make dates, milestones, and turning points easier to understand in a clear visual format. Timetoast is a timeline maker for work, school, research, and stories.